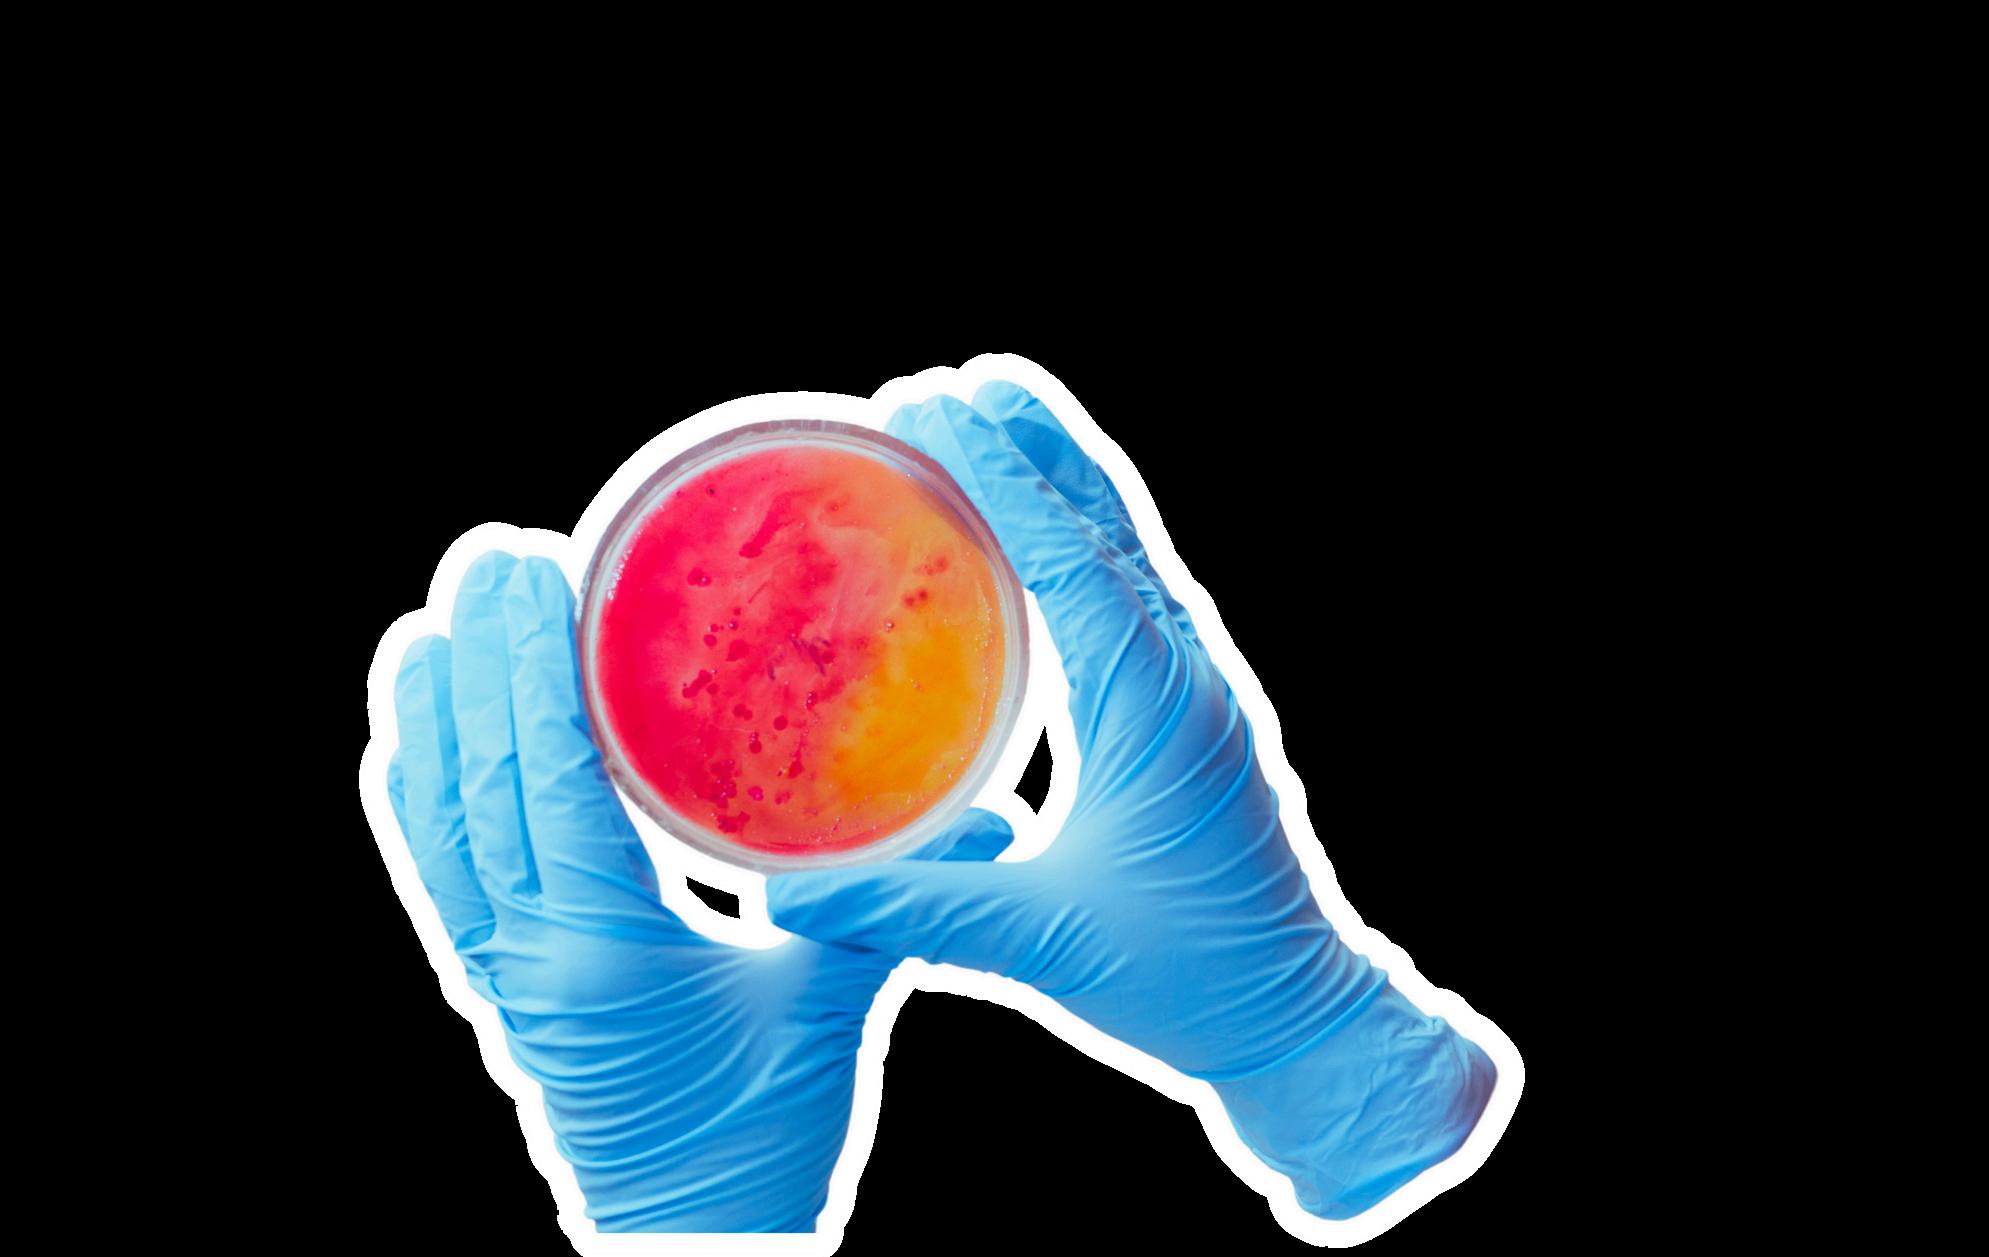

![]()







Milí budúci farmaceuti, úspešná kariéra nevyrastie z večera do rána. Je potrebné sa o ňu starať ako o záhradu, pravidelne ju zalievať, aby v budúcnosti priniesla úrodu. Kariérne dni farmaceutov (KDF), ktoré pre vás už štrnásty rok organizuje Slovenský spolok študentov farmácie, sú tu práve preto, aby vám pripomenuli, že každý z vás má potenciál rásť a rozvíjať sa.
Nasledujúce dni vám Kariérne dni poskytnú možnosť zistiť, ako si začať plniť sny a ambície. Vaše sny sú ako semienko, ktoré musíte zasadiť do správnej pôdy a poskytnúť mu potrebné živiny, aby vykvitlo do nádherného kvetu. V tejto záhrade budú k dispozícii odborníci zo širokého spektra umožňujúci profilovať sa už počas štúdia a tak poskytnúť vašim snom úrodnú pôdu. Počas podujatia budete mať jedinečnú príležitosť stretnúť profesionálov, spoznať potenciálnych zamestnávateľov a objaviť kariérne možnosti, ktoré vám možno doteraz ani nenapadli.
Zasiatie semienka k úspechu je na vás – KDF vám však poskytne pôdu na rozkvitnutie!
Toto podujatie by nebolo možné uskutočniť bez podpory Farmaceutickej fakulty UK v Bratislave, ktorá KDF hostí aj tento rok. Veľká vďaka patrí aj nášmu generálnemu partnerovi, sieti lekární Dr. Max Slovensko, hlavným partnerom - Lekárňam BENU Slovensko, spoločnosti Zentiva, spoločnosti Curaprox, lekárňam Vesnala, sieti lekární EC Pharmacies, spoločnosti Schwabe a spoločnosti UNIPHARMA - 1. slovenská lekárnická akciová spoločnosť, ďalej vystavovateľom: Teva, Interpharm, Saneca Pharmaceuticals, IQVIA, Dr.Max Česká republika, BENU Česká republika, Bonate, NRSYS, Imunoglukan, Lekárňam Váš Lekár či spoločnosti hameln RDS a malým vystavovateľom: New Nordic, Wörwag, Sandoz, Servier, Berlin-Chemie, Krka a Vaša Lekáreň.
Za podporu ďakujeme aj Univerzite Komenského v Bratislave, Štátnemu ústavu pre kontrolu liečiv, Slovenskej lekárnickej komore, GENAS a LIFBEE akadémii.
Bez vás by sme KDF nemohli zorganizovať!
Ak hľadáte svoju profesionálnu cestu, veríme, že tento ročník KDF vám pomôže rozkvitnúť do takej podoby, akú ste si vysnívali.




Čo sú to Kariérne dni farmaceutov?
Farmácia vám otvorila dvere do záhrady možností a teraz je čas rozhodnúť sa, ktorou cestou sa vyberiete. Bude to lekáreň, výskum, klinické skúšanie, regulácia, farmaceutická fima alebo niečo úplne iné?
Kariérne dni farmaceutov (KDF) sú podujatím, ktoré vám pomôže získať prehľad o širokých možnostiach uplatnenia v odbore. Počas KDF sa môžete stretnúť so zástupcami farmaceutických spoločností, klásť im otázky o pracovných príležitostiach, náplni práce či požiadavkách na uchádzačov. Toto je vaša šanca zistiť, čo vás skutočne zaujíma a ktorým smerom sa vydať.
KDF organizuje Slovenský spolok študentov farmácie (SSŠF) v spolupráci s Farmaceutickou fakultou UK v Bratislave ako súčasť Týždňa farmaceutického vzdelávania a kariéry. Podujatie ponúka priestor nielen na networking s potenciálnymi zamestnávateľmi, ale aj na účasť na odborných prednáškach, ktoré vám priblížia nielen aktuálne trendy vo farmácii, ale aj reálne skúsenosti profesionálov, Okrem prednášok a stánkov je KDF plné aj dalších aktivít a súťaží, aby ste vždy mali čo robiť.
Nepremeškajte príležitosť získať cenné informácie a kontakty, ktoré vám môžu pomôcť pri budovaní vašej kariéry. Pýtajte sa, skúmajte možnosti a nájdite si cestu, ktorá vás bude napĺňať. Kariérne dni farmaceutov sú tu práve preto, aby vám pomohli rásť a nechať vašu kariéru rozkvitnúť !
Tešíme sa na vás!
SSŠF Tím
Týždeň farmaceutického vzdelávania a kariéry (TyFaVKa) – najväčšia udalosť organizovaná Slovenským spolkom študentov farmácie, kde sa spája vzdelávanie, kariéra a praktické skúsenosti v oblasti farmácie. Tento týždeň plný zaujímavých aktivít bude zahŕňať aj Kariérne dni farmaceutov (KDF), najväčší farmaceutický job fair na Slovensku. Kariérne dni farmaceutov sú určené pre všetkých študentov farmácie a príbuzných odborov, ktorí hľadajú kariérne príležitosti a chcú sa dozvedieť viac o možnostiach pracovného uplatnenia. Sú ideálnou príležitosťou na získanie prehľadu o farmaceutických spoločnostiach, ich ponukách, ale aj o tom, čo všetko obnáša práca v rôznych oblastiach farmácie. Tento ročník sa uskutoční 10. a 11. marca 2026 na Farmaceutickej fakulte Univerzity Komenského v Bratislave.
Po KDF bude 12. marca 2026 pokračovať TyFaVKa súťažou Majstrovstvá v lekárenskej komunikácii (PCE), kde si študenti budú môcť vyskúšať v rôznych modelových situáciách expedovanie v priestoroch verejnej lekárne. Tento projekt vychádza z kurzu lekárenskej komunikácie a ponúka študentom jedinečnú príležitosť získať praktické skúsenosti ešte pred nástupom na povinnú prax.
TyFaVKa vyvrcholí 20. marca 2026 súťažou Clinical Skills Event (CSE), v ktorej si študenti farmácie a medicíny z rôznych kútov Slovenska preveria svoje schopnosti pri riešení reálnych farmakoterapeutických kazuistík. Víťazi získajú možnosť zúčastniť sa exkurzie na Oddelení klinickej farmakológie Fakultnej nemocnice v Nitre a možnosť absolvovať deň s lekárom v nemocnici AGEL Košice – Šaca. Tieto skúsenosti im umožnia bližšie spoznať prácu klinického farmaceuta, jeho spoluprácu s multidisciplinárnym tímom, a zároveň nahliadnuť z inej perspektívy do každodennej praxe lekára na oddelení.
Nezmeškajte tento unikátny týždeň, ktorý vám otvorí dvere do farmaceutickej praxe















8.30 – 8.40 Otvorenie Kariérnych dní farmaceutov 2026
prof. PharmDr. Ján Klimas, PhD., MPH dekan Farmaceutickej fakulty UK
8.45 – 9.05 Sekcia registrácie liekov
PharmDr. Ivana Pankuchová Štátny ústav pre kontrolu liečiv
9.10 – 9.30 Hodnota generických a biologicky podobných liekov
PharmDr. Michaela Palágyi, PhD. GENAS
9.35 – 9.55 Dr. Max. Dvadsať rokov meníme smer slovenského lekárenstva
Ing. Jaroslav Kypr, Prevádzkový riaditeľ Dr. Max Slovensko
Dr. Max Slovensko
10.00 – 10.30 Prepojenie štúdia a praxe v povolaní farmaceuta: Ako premeniť vedomosti na profesionálnu istotu PharmDr. Petra Klacková, Mgr. Andrea Ťažká BENU Slovensko
10.35 – 10.55 Bez distribúcie niet liečby
Mgr. Matej Varga
UNIPHARMA – 1. slovenská lekárnická akciová spoločnosť
11.00 – 11.20 Kariéra v spoločnosti Teva PharmDr. Jana Tomovič Čačaná TEVA Slovensko
11.25 – 12.00 Liečba respiračných infekcií v pediatrii: Úloha farmaceuta a lekára v multidisciplinárnom prístupe MUDr. Elena Prokopová, hlavná odborníčka Ministerstva zdravotníctva pre primárnu pediatriu Schwabe
12.05 – 12.25 Lekáreň Váš Lekár: kariéra, ktorá má zmysel
Mgr. Aurélia Habová Lekáreň Váš Lekár
12.25 – 13.00 PRESTÁVKA
13.00 – 13.20 Dr. Max pro studenty a absolventy Mgr. Barbora Přikrylová Dr. Max Česká republika
13.25 – 13.55 Kariéra, ktorá dáva zmysel: Prečo som si vybral farmáciu a Zentivu ZENTIVA a. s.
14.00 – 14.20 Farmaceut ako odborník, školiteľ a ambasádor Mgr. Lívia Jendrálová a jej kariérna cesta v Dr. Max Dr. Max Slovensko
14.25 – 14.45 Spoznajte EC Pharmacies – naša vízia a hodnoty Klaudia Kruľová a Róbert Kardoš EC Pharmacies
14.50 – 15.10 S čím sa pravdepodobne stretnete v praxi PharmDr. Zdeněk Nouzovský INTERPHARM
15.15 – 15.35 Saneca Pharmaceuticals a.s. Cesta od tradičných liekových foriem k sterilnej výrobe Ing. Veronika Boriková Saneca Pharmaceuticals a.s.
15.40 – 16.00 Vedecké inovácie a startupy zlepšujúce ľudské zdravie (a čo vieme robiť na Slovensku) Jakub Malachovský Lifbee Academy
16.30 – 19.00 RECEPCIA KDF 2026
9.00 – 9.20 Zelená, efektívna a moderná: backstage farmácie.
Autenticitou k úspechu – od dát a procesov až k pacientovi
Ing. Karolína Froncová ZENTIVA a. s.
9.25 – 9.45 Začni svoju kariéru už počas štúdia: stáže, prax a štipendiá v BENU Mgr. Eva Síkorová
BENU Slovensko
9.50 – 10.10 Na Vašu Lekáreň a MED-ART sa môžete spoľahnúť PharmDr. Petra Haár Némethová,
PharmDr. Marek Macejko Vaša lekáreň
10.15 – 10.45 Farmácia trochu inak. Takto to robíme v Dr. Max PharmDr. Erik Novanský a Mgr. Lukáš Petrok
Dr. Max Slovensko
10.50 – 11.20 Čo vám nikto nepovie o práci farmaceuta Mgr. Jakub Držík a Mgr. Matej Gáľ
EC Pharmacies
11.25 – 11.45 hameln rds Modra – Galenický vývoj
PharmDr. Kamila Bartoníková, PhD. hameln rds
11.50 – 12.40 Farmaceuti v prvej línii prevencie ústneho zdravia MDDr. Boris Kotúľ CURAPROX
12.45 – 13.05 Pleuran – 25 rokov súčasťou Vašej rodiny Mgr. Martin Pinček IMUNOGLUKAN s. r. o.
13.05 – 13.30 PRESTÁVKA
13.30 – 13.50 Kariéra v Bonate
Mgr. Petr Karnas Bonate
13.55 – 14.15 Lékárník 21. století Mgr. Jana Lámošová, Mgr. Aleš Luňák BENU Česká republika s. r. o.
14.20 – 14.40 eZdravie v lekárenskej praxi Mgr. Juraj Svitač NRSYS s. r. o.
14.45 – 15.05 Oddelenie postregistračnej kontroly Mgr. Simona Paľovčíková Štátny ústav pre kontrolu liečiv
15.10 – 15.30 Klinický výskum ako kariérna cesta s IQVIA Andrea Beránková IQVIA

POLIEVKA: Hrachová so zeleninou
MENU:
č. 1: Segedínsky guláš s domácou parenou knedľou
č. 2: Kurací wok so zeleninou, ryža
č. 3: Kurací rezeň s pečenými zemiakmi, šalát
č. 4: Cestovinový šalát s pečenou zeleninou, tofu, dressing
POLIEVKA: Zemiaková s vajíčkom na kyslo
MENU:
č. 1: Bravčový rezeň v parmezánovej strúhanke s ryžou
č. 2: Kuracie rizoto zo slovenskej ryže, syr
č. 3: Mix šalát s kuracími nugetkami, dressing
č. 4: Zeleninový paprikáš s kokosovým mliekom, cestovina


Hľadáš príležitosti, ktoré Ťa posunú ďalej
už počas štúdia, ale aj po ňom?
My ich máme a čakajú práve na Teba.
Dr. Max je Tvojím štartovacím bodom k úspešnej
kariére či si študent, čerstvý absolvent, alebo premýšľaš nad tým, kam po škole.
NAŠE PROGRAMY PRE ŠTUDENTOV
PODNIKOVÉ ŠTIPENDIUM
Ako štipendista v Dr. Max dostaneš 200 € mesačne, vďaka čomu sa môžeš viac sústrediť na štúdium. Podpora, ktorá Ti uľahčí školu a zároveň Ti otvorí dvere k budúcej kariére.
ODBORNÁ PRAX
Naša sieť má viac ako 120 výučbových lekární po celom Slovensku, ktoré poskytujú kvalitné odborné vedenie a stabilné zázemie pre študentov farmácie. Počas praxe budeš pracovať po boku skúseného personálu. Získaš podporu odborníkov, ktorí Ti odovzdajú praktické knowhow, naučia Ťa správne postupy a pomôžu Ti vybudovať profesionálnu istotu v práci.
A ako bonus, v prípade, že absolvuješ celú odbornú prax v Dr. Max, po nástupe
do pracovného pomeru Ti vyplatíme odmenu 1500 € ako férové ocenenie za Tvoju snahu a dlhodobú spoluprácu.
ZÁŽITKOVÁ FARMACEUTICKÁ STÁŽ
Získaš prístup tam, kam sa bežný študent nedostane. Počas programu detailne spoznáš fungovanie centrály, procesy eshopu, aj zákulisie distribučnej spoločnosti ViaPharma. Uvidíš, ako jednotlivé tímy spolupracujú, ako vznikajú rozhodnutia a čo všetko stojí za úspechom najväčšej lekárenskej siete na Slovensku.
BRIGÁDA PRISPÔSOBENÁ TVOJMU ROZVRHU
Uvedomujeme si náročnosť štúdia farmácie. Preto ponúkame flexibilnú brigádu, ktorá rešpektuje Tvoj rozvrh, skúškové obdobie aj ďalšie povinnosti. Získaš odborné skúsenosti, finančný príjem a možnosť postupne sa adaptovať na prax v lekárni.
ČO PONÚKAME ABSOLVENTOM?
Trvalý pracovný pomer na dobu neurčitú
Pozície: FARMACEUT REGIONÁLNY FARMACEUT
jovT a b u d úcnosťvo


PREČO SI VYBRAŤ PRÁVE Dr. Max?
• Férové finančné ohodnotenie
• Vzdelávanie formou Akadémia Dr. Max
• Adaptačný proces
• Výber zo 440 lekární po celom Slovensku
• Rôzne typy lekární (poliklinické, streetové, shoppingové)
• Zamestnanecké zľava v lekárňach Dr. Max
• Široká škála benefitov z Cafetéria systému
• Neustále zlepšovanie procesov a inovácie, ktoré umožňujú nášmu personálu sústrediť sa na pacienta
• Staneš sa súčasťou tímu profesionálov, pre ktorých je odbornosť rovnako dôležitá ako ľudský prístup
Zaujalo Ťa niečo a chceš viac informácií?
Kontaktuj nás na kariera@drmax.sk
Prečítajte si rozhovor s našim kolegom z lekárne, Mgr. Denisom Juhásom, ktorý je absolventom 2025
FaF UK v Bratislave. Denis u nás pracoval už počas štúdia, absolvoval u nás odbornú prax a poberal aj podnikové štipendium, ktoré poskytuje Dr. Max Slovensko.


Absolvent Farmaceutickej fakulty
Univerzity Komenského v Bratislave, štúdium ukončené v roku 2025, aktuálne zamestnanie lekáreň Dr. Max v Bratislave.
Čo by si odkázal niekomu, kto zvažuje
štipendium alebo odbornú prax v Dr. Max?
Určite by som štipendium odporučil – s dobrým študijným priemerom je dostupné a má viacero výhod. Dr. Max ponúka rôzne typy lekární a pracovných režimov, takže si každý vie nájsť to, čo mu vyhovuje. Veľkým plusom je aj možnosť vybrať si konkrétnu lekáreň, v ktorej chcete po škole pracovať.
V čom bolo pre Teba prínosné poberanie štipendia?
Štipendium je príjemná možnosť, ako mať počas neplatenej praxe dostatok financií na pohodlie. Človek si vie peniaze odložiť, investovať do ďalšieho vzdelávania alebo ich využiť na bežné potreby či oddych. Jednoducho a prakticky.
Čo Ťa počas odbornej praxe najviac zaujalo alebo prekvapilo?
Zaujímavou skúsenosťou pre mňa boli takzvaní „lietajúci“ farmaceuti, ktorí pracujú vo viacerých lekárňach v rámci regiónu. Majú širší zámer, spoznávajú rôzne kolektívy aj pacientov a vidia prácu z viacerých uhlov. Je to dobrý spôsob, ako získať nadhľad a nové skúsenosti.
Spomenieš nejakú vtipnú alebo nezabudnuteľnú situáciu z praxe? Vtipných situácií bolo naozaj veľa.
Spočiatku som si často mýlil produkty privátnej značky, pretože ich je veľké množstvo. Dnes sa na tom s kolegami už len smejeme – a paradoxne mi teraz ani nepríde, že by ich bolo až tak veľa.
Čo bolo pre Teba počas praxe najzaujímavejšie?
Mal som možnosť vyskúšať si prácu v streetovej, shoppingovej aj poliklinickej lekárni. Vďaka tomu som si vedel ujasniť, ktorý typ prostredia mi vyhovuje najviac.
Hoci sú pacienti všade rôzni, starostlivosť, ktorú im poskytujeme, zostáva rovnaká.
Prečo si si vybral práve Dr. Max ako svojho budúceho zamestnávateľa?
Keďže som absolvent gymnázia, nemohol som hneď pracovať v lekárni naplno, preto som začal formou brigády. Práca v lekárni ma už vtedy lákala a chcel som si ju reálne vyskúšať, čo určite odporúčam aj ostatným študentom. Približne v druhom ročníku farmácie som si uvedomil, že odbornú prax chcem absolvovať práve v Dr. Max a prirodzene v tom pokračovať.
V akej lekárni aktuálne pracuješ?
Pracujem v lekárni Dr. Max v nákupnom centre v Bratislave. Denne riešim rôzne typy predpisov a stretávam pacientov s odlišnými potrebami. Často prichádzajú aj zahraniční pacienti, takže komunikácia v cudzích jazykoch je u nás úplne bežná. Vďaka tejto pestrosti práca nepôsobí stereotypne.
Zaujalo Ťa niečo a chceš viac informácií?
Kontaktuj nás na kariera@drmax.sk
V čom je pre Teba výhoda práce v 12-hodinovej lekárni?
Vyhovuje mi striedanie krátkeho a dlhého týždňa, vďaka čomu si viem lepšie plánovať voľno aj dovolenky. Počas týždňa si človek vie vybaviť veci, na ktoré by inak nemal čas. Veľmi dôležité je aj to, s akými kolegami tie dvanásť hodinové zmeny trávite – dobrý tím je veľká výhra.
Aká bola Tvoja prvá skúsenosť s pacientom?
Bola hneď počas prvého týždňa lekárenskej praxe. Pacientka si prišla po lieky na recept a zároveň potrebovala francúzske barle na poukaz. Pomohol som jej s nastavením barlí, vydal lieky a odchádzala spokojná – pre mňa veľmi príjemný začiatok.
Čo by si vyzdvihol na práci v lekárňach Dr. Max?
Najviac si vážim jednotný systém práce, kolegiálne prostredie a možnosti ďalšieho vzdelávania. K tomu sa pridávajú rôzne benefity, ktoré robia prácu komfortnejšou a dlhodobo udržateľnou.
Aké sú Tvoje kariérne ciele do budúcna?
V najbližšom období by som sa chcel prihlásiť na rigorózne konanie. Neskôr sa chcem rozhodnúť podľa času a chuti, či pôjdem cestou atestácie, alebo sa posuniem iným smerom. Nechávam si otvorené možnosti.

• pomôžeme ti s adaptáciou • môžeš sa vzdelávať a rozvíjať • ponúkame ti stabilitu a istotu

Pomôžeme ti vyrásť

Študuj naplno s podporou 200 €
mesačne už od 4. ročníka a získaj istotu práce v BENU hneď po štátniciach. Žiadosť o finančnú injekciu pre tvoj rast pošli do 30. apríla.
Premeň teóriu na reálnu skúsenosť v našich výučbových lekárňach po celom Slovensku. Za 3 mesiace povinnej praxe v 5. ročníku získaš pri následnom nástupe do tímu bonus 1 000 €.
Absolvuj u nás voliteľný predmet v spolupráci s FaF UK Bratislava a získaj kredity. Pozor, kapacita je limitovaná.
Zarob si popri štúdiu v lekárni blízko tvojho domova alebo internátu s časom, ktorý sa plne prispôsobí tvojmu rozvrhu. Pridaj sa k BENU rodine na kariera@benulekaren.sk alebo www.benukariera.sk.
Ak veríš, že povolanie lekárnika nestojí len na odbornosti, ale aj na ľudskom prístupe, u nás si na správnom mieste. Vo Vesnala lekárňach dostaneš priestor učiť sa praxou, pracovať samostatne a rásť bez zbytočného tlaku.
Budeš súčasťou tímu, kde sa rešpekt, dôvera a otvorená komunikácia berú ako samozrejmosť. Ak chceš pracovať v prostredí, kde môžeš zostať sám/sama sebou a robiť lekárenstvo zmysluplne, radi ťa spoznáme.
Viac o práci vo Vesnala Lekárni nájdeš na kariera.vesnala.sk

AŽ DO 8 000 €
Nástupný bonus až 8 000 €
Dvojnásobné príplatky za prácu cez víkend
Príspevok na svadbu a pri narodení dieťaťa
Príspevok na cestovanie
Narodeninový a vianočný bonus
Preplatenie poplatkov do lekárnickej komory
Multisport karta
Teambuildingy a občerstvenie
Flexibilné plánovanie zmien
Sloboda v expedícii produktov
Hoci pod názvom Vesnala nás poznáte len chvíľu, prvú lekáreň sme otvorili ešte v roku 2010. Odvtedy máme už 14 lekární a pribúdajú ďalšie. Vo Vesnala Lekárňach pracujeme v malých tímoch. Otvorene spolu komunikujeme a dbáme na to, aby naši zamestnanci cítili v práci slobodu a mali férové podmienky.

Barbora Kolejáková
Chief Resources Officer +421 901 744 443 barbora.kolejakova@vesnala.sk
Brezno
Banská Bystrica
Chor vátsky Grob
Bratislava 3×
Viac o práci vo Vesnala Lekárni nájdeš na kariera.vesnala.sk
Rovinka
Trnava 3× Sereď
Nové Zámky

Pri výbere zubnej kefky sa väčšina ľudí riadi cenou alebo tvrdosťou vlákien. Len málokto však rieši, z akého materiálu sú vlákna vyrobené. Práve ten má pritom zásadný vplyv na šetrnosť čistenia a dlhodobé zdravie zubov a ďasien. Nová laboratórna štúdia porovnala tradičné nylonové vlákna , ktoré sa používajú aj vo všetkých kefkách Curaprox.
Tvrdé alebo nestabilné vlákna môžu pri každodennom čistení spôsobovať mikroškrabance na sklovine, zvýšenú citlivosť zubov či ústup ďasien. Nylon je pevný a rozšírený materiál, no vo vlhkom prostredí absorbuje vodu, čím v kefkách Curaprox je špeciálny polyesterový materiál, ktorý vodu takmer neabsorbuje, a preto si zachováva
Vedci pomocou špeciálnych prístrojov simulovali až šesť mesiacov pravidelného čistenia zubov. Porovnávali pevnosť a opotrebenie vlákien, ako aj ich
Výsledky ukázali, že nylonové vlákna boli tvrdšie a agresívnejšie k povrchu zubov, čo zvyšovalo mechanické poškodenie skloviny. Vlákna Curen® v kefkách Curaprox boli pružnejšie a výrazne šetrnejšie. Po simulovanom čistení bol povrch skloviny pri použití Curen® hladší, zatiaľ čo nylon zanechával povrch drsnejší.

Dlhšia životnosť kefky
Nylonové vlákna sa pri dlhodobom používaní rýchlejšie deformovali a rozchádzali. Vlákna Curen® v kefkách Curaprox si zachovali svoj tvar lepšie a rozstrapkali sa približne o tretinu menej, čo znamená potenciálne až dvojnásobne dlhšiu účinnosť kefky.

Záver pre prax Štúdia potvrdzuje, že materiál vlákien zohráva dôležitú úlohu pri ústnej hygiene. Kefky Curaprox s jemnými a stabilnými vláknami Curen® umožňujú účinné, no zároveň šetrné čistenie zubov, čo by malo zohrať úlohu pri odporúčaní pacientom v lekárni.
Ak chcete dať vysokoškolskej kapitole ďalší rozmer, Curaprox má pre vás skvelú príležitosť – staňte sa školiteľmi projektu Dental Alarm. Ten učí žiakov v školách a škôlkach, ako sa starať o zuby správne, pravidelne a s radosťou.
Pomáhajte deťom a tínedžerom k zdravším úsmevom, privyrobte si naozaj zmysluplným spôsobom a popri tom zbierajte parádne zážitky.

Čo vás čaká?


• mzda: junior školiteľ/ka 8 €/hod, senior školiteľ/ka 10 €/hod
• firemné auto na cesty za školením
• preplatené cestovné náklady a čas strávený na ceste
• zľavu 35% na všetky produkty Curaprox
Viac info na dentalalarm.sk.

V Zentive poskytujeme zdravie a wellbeing pre všetky generácie
Vyvíjame, vyrábame a dodávame kvalitné a cenovo dostupné lieky pre viac ako 100 miliónov ľudí vo viac ako 30 krajinách Európy a mimo nej. Náš tím 5 000 jedinečných talentov zdieľa záväzok voči ľuďom, ktorí sa každý deň spoliehajú na naše lieky.
Na čo sa môžete tešiť?
• Na veľa informácií od našich kolegov ohľadne kariérnych možností. Mnohí z nich sú absolventmi Vašej školy.
Zo spoločnosti Zentiva Vás privítajú:
PharmDr. Lenka Zálešáková, Medical representative; Mgr. Ľubomíra Petényi, HR Administration & Payroll Manager;

• Na prednášku nášho kolegu z Trade Chain Mgr. Michal Kaščáka a tiež na prednášku našej kolegyne z Business Excellence Ing. Karolíny Froncovej.
• Na množstvo ďalších informácií a odpovedanie na Vaše otázky.
Tešíme sa na Vás!

PharmDr. Matej Fábry, Affiliate Quality Manager/Responsible Pharmacist; Mgr. Katarína Herbortová, Senior District Manager Mgr. Miroslav Hufka, Medical Representative
PharmDr. Mariana Kuziaková, Regulatory Affairs Specialist ; Mgr. Alžbeta Ižofová, Regulatory Affairs Specialist; Tímea Rentka , HR & General Services ; Bc. Lenka Nagyová, Executive Assistant GM
Naším poslaním je zabezpečiť zdravie a wellbeing pre všetky generácie, pričom sa riadime piatimi kľúčovými hodnotami.
Naše hodnoty usmerňujú naše konanie a posilňujú náš dlhodobý záväzok.










Zentiva založilaa je hlavným partneromvýskumného inštitútuThe Parc, ktorý má sídloa pôsobeniev pražskejcentrálea ktorýponúka postgraduálneškoleniavo farmaceutickomvýskume, študentskéstáže a výmenu vedeckého know-how. Parc ponúka akademickévzdelanie svetovej triedy v kombináciis praktickýmiskúsenosťamiz priemyslu a obchodupod vedením vedcov, inžinierova manažérovz akademickej obce a farmaceutickéhopriemyslu.
Zentiva aktívne spolupracuje s domácimi výskumnými inštitúciami a univerzitami.

Spoločnosť Dr. Wilmar Schwabe je svetovým lídrom v oblasti výskumu, vývoja a výroby rastlinných liekov - fytofarmák.

Štandardizované zloženie liekov
160 rokov na trhu
Pre celú rodinu
Všetky aktuálne informácie a pracovné ponuky môžete sledovať na našom LinkedIn profile @Schwabe Slovakia a webe www.schwabe.sk. www.schwabe.sk

@Schwabe Slovakia

Počas KDF 2026 si môžete vypočuť zaujímavé prednášky mnohých odborníkov. Pozývame vás aj na tú našu.
Zo spoločnosti Schwabe Slovakia sa na vás tešia kolegovia, ktorí veľmi radi zodpovedia všetky vaše otázky týkajúce sa našej spoločnosti, produktov, či prípadnej spolupráce.


UŽ 160 ROKOV
Celý výrobný proces, od pestovania a zberu liečivých rastlín, ktoré vstupujú do našich výrobných zariadení, až po hotové výrobky, ktoré poskytujeme našim zákazníkom, je v našich rukách. Tento nezávislý prístup zaručuje výnimočnú kvalitu našich liekov, ktoré musia spĺňať rovnaké štandardy ako syntetické lieky. Tieto štandardy kvality dosahujeme vo všetkých fázach výrobného procesu.
Vysoká kvalita našich špeciálnych extraktov a pevné vedecké základy na výrobu a klinické testovanie našich produktov sú rozhodujúcimi faktormi, ktoré robia z Dr. Willmara Schwabe svetovo významného experta na rastlinné lieky.
Okrem výroby sa spoločnosť venuje aj výskumu a vývoju rastlinných liečiv.
Veríme, že práve fytofarmaká budú čoraz populárnejšie a pomôžu ľuďom na celom svete viesť udržateľný, produktívny a zdravý život.
Spoločnosť Schwabe Slovakia je na Slovensku aktívna od roku 1996. Zabezpečuje marketing liekov a výživových doplnkov rastlinného pôvodu. Materská spoločnosť
Dr. Willmar Schwabe GmbH & Co. KG je jedným z najstarších výrobcov farmák v Európe. Jej história sa datuje už 160 rokov!
Sú to najmä naši zamestnanci – ich skúsenosti, tvorivosť a naša spoločná vízia, ktorú zdieľame, s mottom:


Schwabe Slovakia s.r.o. Einsteinova 33, 851 01 Bratislava tel.: +421 2 52 924 583, e-mail: info@schwabe.sk, www.schwabe.sk




















































+ Špičkové vzdělávání
Budeš mít vstup zdarma na Akademii Dr. Max a přístup ke stovkám e-learningovým vzdělávacím lekcím pro Tvůj odborný rozvoj.
+ S námi najdeš ideální balanc!
Zvýhodněné vstupenky do divadel, vstupenky na závody Běhej lesy a Jizerská 50, zajímavé akce pro zaměstnance a jejich rodiny, výhodné nabídky třetích stran:
Alza, O2, Škoda, Datart a další...
+ Jedinečné benefity
Služební byt nebo příspěvek na bydlení, 5 týdnů dovolené + CARE days, Multisport karta jen za 10 EUR měsíčně, stravenky ve výši 9 EUR a další benefity:
Přidej se k nám!






































KVALITA





ČISTOTA ÚČINNOSŤ


NÁŠ 360° PRÍSĽUB KVALITY:























BIOLOGICKÁ
DOSTUPNOSŤ




























































Neúnavná snaha o dokonalosť od roku 1922. V spoločnosti Jamieson kvalita nie je len slovo. Je hnacou silou všetkého, čo robíme. A robíme to tak už viac ako 100 rokov. Od vysokej zodpovednosti na strane našich ľudí, cez starostlivosť pri výbere vysokokvalitných surovín od dôveryhodných dodávateľov, až po dôkladné testovacie metódy v každom kroku výroby. Výsledkom sú kvalitné výrobky Jamieson, ktoré sú testované, bezpečné a účinné. Zaväzujeme sa, že v našom prísľube kvality nikdy nepoľavíme.
Logo super kvality.













Logo 360° Quality symbolizuje náš nikdy nekončiaci záväzok pozerať na kvalitu zo všetkých uhlov, v celom procese od výroby až po uvedenie do predaja, ktorý zabezpečuje testované, bezpečné a účinné produkty, ktorým spotrebitelia môžu dôverovať.
VÝVOJ
ZLOŽENIA
Dovoz a distribúcia v SR: INTERPHARM Slovakia, a. s., Uzbecká 18/A, 821 06 Bratislava
Infolinka: 02/40 200 400
www.jamieson.sk
ZÍSKAVANIE
SUROVÍN
rozhoduje
ŠTANDARDY
TESTOVANIA

PROCESY VÝROBY
facebook.com/JamiesonSlovensko instagram.com/jamieson_vitaminy Žiadajte v lekárňach!
































BP B3 AFIB + IHB Digitálny tlakomer
























AFIB – „Detekcia predsieňovej arytmie (atriálna fibrilácia) pre včasnú prevenciu cievnej mozgovej príhody.“











BP A2 Classic Digitálny tlakomer






















NEB 210 ACTIVE
Kompresorový inhalátor

Inovatívny inhalačný systém pre efektívnu liečbu































































Bezdotykové infra teplomery






















NEB 400 / 410 Detský inhalátor s hravým dizajnom


dlhodobá podpora imunitného systému v priebehu celého roka v tekutej forme pre mladšie deti
vo forme cmúľacích tabliet a kapsúl pre staršie deti a dospelých dávkovanie 1x denne
1Vitamín C, vitamín D a zinok prispievajú k správnemu fungovaniu imunitného systému


Naskenuj QR kód a staň sa členom Imunoklubu
Rovnováha medzi stresom a imunitou
IMG®/Imunoglukan® je vysoko purifikovaná prírodná látka izolovaná z hlivy ustricovitej (Pleurotus ostreatus), komplex biologicky aktívnych polysacharidov s majoritným zastúpením beta-(1,3/1,6)-D-glukánu pleuran. Účinnosť a bezpečnosť produktov Imunoglukan P4H® je overená 25 ročnou prítomnosťou na trhu a vlastnou databázou evidence-based medicine, ktorá pozostáva z viac ako 70 klinických štúdií a pozorovaní uskutočnených či už s detskou populáciou, zdravými dobrovoľníkmi, chronicky chorými pacientami, seniormi až po vrcholových športovcov. Kombináciou IMG® a vitamínu C dochádza k synergickej podpore imunitného systému aktiváciou nešpecifickej (vrodenej) a špecifickej (získanej) imunity. Vrodená imunita má schopnosť formovať imunitnú pamäť nazývanú trénovaná imunita. Trénovaním imunity dochádza k preprogramovaniu buniek (napr. monocyty, makrofágy, NK bunky), čoho výsledkom je, že organizmus rýchlejšie a intenzívnejšie reaguje v obrane pred vznikom infekcie spôsobenej rôznymi patogénmi. Beta-glukány patria medzi vedecky preskúmané induktory trénovanej imunity.
Mentálny a fyzický stres

40 rokov nepretržitého klinického výskumu
patentovaný technologický proces výroby
slovenský výrobok s expanziou do 36 krajín sveta
excelentný bezpečnostný profil bez liekových interakcií
IMG® nevstupuje do krvného obehu
vhodý pre deti od 3 rokov, dospelých a aktívnych športovcov neobsahuje laktózu ani glutén
Chronický stres vedie k trvalo zvýšeným hladinám hormónov, glukózy a lipidov v krvi. Často je spojený s nezdravým životným štýlom, čo postupne oslabuje obranné mechanizmy organizmu. Dlhodobý stres má negatívny vplyv na imunitný systém, čo spôsobuje imunosupresiu a zvyšuje riziko infekcií. Fyzický stres je spojený s telesnými faktormi, ako sú choroby, úrazy, nadmerná záťaž športovcov alebo iný druh telesného diskomfortu. Opakovaná fyzická námaha bez dostatočnej regenerácie môže viesť k trvalejšiemu oslabeniu imunitného systému, tzv. imunosupresívne okno.
recidivujúce infekcie
zvýšený psychický stres
dýchacích ciest
zvýšená fyzická námaha
pred nástupom detí do kolektívu rekonvalescencia
alergické choroby
dýchacích ciest
akútne respiračné ochorenia herpes simplex atopický ekzém a iné kožné ochorenia ochorenia tráviaceho traktu
Věříme, že lékárna může být přirozeným místemprevence.ProgramVROVNOVÁZE
vznikl ve spolupráci s odborníky a pod záštitou České obezitologické společnosti ČLSJEP.Reagujenarostoucívýskytnadváhy, obezityacivilizačníchonemocněníanabízí smysluplnýnástroj,jakpacientůmpomoci dlouhodoběaodborně.
TVŮJPROSTORPROROZVOJ
Unásmášmožnostrozvíjetseimimotradiční rolilékárníka.Můžešsezapojitdokonzultační činnosti,pracovatspacientyvprevenci avyužívatsvéodbornéznalostivpraxi.Jeto příležitoststátselékárníkem,kterýmáreálný dopadnazdravílidíaaktivněsepodílína modernímpojetílékárenství.

profeselékárníkasilnoubudoucnost.Věřím,žeizastoletbudoupacientido lékárenchodit–ikdyžnašeprácebudepravděpodobněvypadatúplnějinak.Budu mocrád,pokudsekemněamýmkolegůmnatétocestěpřipojíte. ��
2018–NástupdoBENU
2019–Zapojenísedoscreeningovýchprogramůvlékárně
2021–Zástupcevedoucíholékárníka
2022–Lékárník–konzultantvCentrechprevence(duben)
2022–Vedoucílékárník(červen)

VšechnycestyvedoudoBENU!



IQVIA je medzinárodným lídrom v oblasti informatiky v zdravotníctve a riešení pre farmaceutický priemysel.
V tejto oblasti poskytujeme špičkové služby, ktoré pomáhajú našim zákazníkom zlepšovať kvalitu života a zdravotný stav pacientov na celom svete.
Naša rozsiahla ponuka služieb zahŕňa klinické štúdie, skúsenosti z reálneho sveta, poradenstvo v oblasti regulácií a ďalšie.
Vďaka našim údajom, analytickým nástrojom a odbornému zázemiu pomáhame našim zákazníkom vytvárať efektívne stratégie a dosahovať ich ciele.

Naskenujte si QR kód a vyplňte základné informácie, ak chcete ostať v kontakte a dostať informácie o vhodných pozíciách, ako prvý alebo nás navštívte na jobs.iqvia.com
Rozhovor s Andreou Beránkovou, Clinical Research Associate v spoločnosti IQVIA RDS Slovakia
Andrea, vieme, že si absolventkou farmaceutickej fakulty. Môžeš nám prezradiť, ako si sa k tejto práci dostala a ako si sa dozvedela o spoločnosti IQVIA?
O spoločnosti IQVIA som sa dozvedela na Kariérnych dňoch farmaceutov. Práca monitorky je veľmi zaujímavá a dynamická. Ako monitor mám na starosti konkrétne štúdie a centrá klinického výskumu. Mojou prácou je dohliadať na to, aby štúdia prebiehala v súlade s protokolom a správnou klinickou praxou. Centrá navštevujem osobne a vďaka tomu mám možnosť precestovať celé Slovensko. Pred každou vizitou je dôležitá dôkladná príprava a po vizite podrobná správa o aktuálnom stave centra.
vyzerá Tvoj deň?
Každý inak. Aj preto je pre mňa táto práca zaujímavá. Prácu by som rozdelila na dni na centre a mimo centra. Pokiaľ mám vizitu na centre, tak sa venujem pacientskej dokumentácii, kontrole liekov, ich správnemu skladovaniu. Ďalej sledujem, či centrum vykonalo všetky procedúry a vyšetrenia v súlade s protokolom štúdie a správnou klinickou praxou. Dni mimo centra sú viac o administratíve – je potrebné spísať všetky výstupy z vizity do správy. V prípade nájdených chýb alebo nezrovnalostí komunikujem s projektovým tímom, klinickým lídom, centrom a hľadáme riešenia na čo najrýchlejšie odstránenie problému. Dôležitou súčasťou práce je aj príprava na ďalšie vizity, študovanie dokumentov a protokolu. Monitor je osobou prvého kontaktu pre centrum a preto sa dni odvíjajú aj od toho, ako často zazvoní telefón.
Bolo vždy Tvojím prianím pracovať v oblasti klinického výskumu?
Práca monitora ma oslovila ešte počas štúdia na farmaceutickej fakulte. Približne od druhého ročníka som vedela, že by som chcela byť monitorka. Zaujalo ma, že ako farmaceut viem svoje vedomosti využiť aj pri klinickom výskume liečiv. Páčila sa mi aj predstava, že viem prácu spojiť s cestovaním po krajine.
Práca monitorky klinických skúšaní vyžaduje veľa organizačných a komunikačných schopností. Máš návod ako sa to všetko dá zvládnuť?
Už štúdium na farmaceutickej fakulte ma pripravilo na organizáciu môjho času. Je dôležité určiť si priority a naplánovať činnosti. Musím sa priznať, že je to niekedy náročné. Najmä keď mám niečo naplánované a musím plány zmeniť kvôli aktuálnej urgentnej situácii. Flexibilita je pri práci monitora veľmi dôležitá.
Čo Ťa na tejto práci najviac uspokojuje a motivuje pokračovať?
Vízia, že pomáham pacientom a aj vďaka mojej práci sa dostávajú inovatívne lieky bližšie k ľuďom. V konečnom dôsledku pacient, jeho zdravie a bezpečnosť, sú vždy na prvom mieste. Ďalej sa mi na mojej práci páči, že mám priestor rozvíjať sa – či už v rôznych terapeutických oblastiach alebo v nových procesoch, ktoré štúdie prinášajú. Klinické skúšanie je veľmi dynamický proces, ktorý so sebou prináša častokrát veľké výzvy, ale aj pocit zadosťučinenia, že robíme svet pre pacientov lepším.
Ďakujem, Andrea, za rozhovor, a prajem Ti ešte veľa ďalších úspešných projektov a spokojnosti v práci monitorky.





Farmaceuti dnes stoja na kľúčovom mieste medzi zdravotníckymi odborníkmi – sú prvými, na koho sa pacienti často obracajú s otázkami týkajúcimi sa liečby, interakcií liekov či správneho užívania liekov. Kvalita ich odborných rád však priamo závisí od toho, ako aktuálne a komplexné informácie majú k dispozícii. Práve preto je pravidelné vzdelávanie zásadné pre každodennú prax aj pre bezpečnosť pacientov.
Farmaceut, ktorý sa priebežne vzdeláva, dokáže lepšie identifikovať rizikové situácie, upozorniť na kontraindikácie alebo upozorniť pacienta na správne dávkovanie liekov či výživových doplnkov. Moderná farmakoterapia navyše prináša stále nové lieky a inovatívne terapeutické prístupy, ktoré vyžadujú kontinuálne dopĺňanie znalostí. Aktívny prístup k vzdelávaniu tak posilňuje nielen profesionalitu farmaceutov, ale aj dôveru pacientov, ktorí hľadajú spoľahlivého partnera pri starostlivosti o svoje zdravie.
Dôležitou súčasťou odbornej úlohy farmaceuta je aj edukácia pacientov. Správne vedená komunikácia pomáha zvýšiť adherenciu k liečbe, minimalizovať riziká spojené s nesprávnym užívaním liečiv a podporovať prevenciu. Farmaceut teda nie je iba osobou, ktorá lieky vydáva, ale aj poradcom, ktorý dokáže pacientovi zrozumiteľne vysvetliť podstatné informácie a motivovať ho k zodpovednej starostlivosti o vlastné zdravie
Pre podporu kontinuálneho vzdelávania zdravotníckych pracovníkov vznikajú špecializované platformy, ktoré poskytujú kvalitné, odborne spracované vzdelávacie materiály.
Medzi ne patrí napríklad portál www.kapitoly‑online.sk určený pre zdravotníckych odborníkov. Tento multiodborový portál s desaťročnou históriou poskytuje unikátne informácie, ktoré nenájdete nikde inde.
Pre širokú verejnosť je potom určená platforma www.kapitolyozdravi.sk, ktorá pomáha pacientom lepšie porozumieť svojmu zdraviu a liečbe – a zároveň slúži farmaceutom ako cenný zdroj pri ich edukácii. Tento portál pre pacientov je garantovaný odborníkmi z mnohých terapeutických oblastí.
Investícia do vzdelávania farmaceutov je investíciou do bezpečnejšej a kvalitnejšej starostlivosti. Odborné znalosti, zrozumiteľná komunikácia a dôraz na prevenciu predstavujú kľúč k zvyšovaniu zdravotnej gramotnosti pacientov i k posilňovaniu ich dôvery v zdravotnícky systém.






Advanced Training In Pharmacy Care
Farmaceutická fakulta UK, Slovenský spolok študentov farmácie a farmaceutická spoločnosť Wörwag Pharma Slovensko s.r.o. v 11. ročníku projektu ponúkajú








získanie vedomostí a hlavne praktických zručností pred nástupom do praxe,
skvalitnenie dispenzačnej a poradenskej činnosti pri liečbe aj samoliečbe pacientov,
vytvorenie úspešnej a dlhoročnej spolupráce akademického a podnikateľského subjektu.
PRE KOHO JE URČENÝ?
pre maximálne 7O študentov 4. ročníka
2-dňový tréning zameraný na získanie odborných a praktických zručností v oblasti správnej dispenzačnej praxe orientovanej na pacienta, apríl/2O26, na našej fakulte
praktická časť projektu, október/2O26, v mieste výkonu Tvojej praxe

• podporujeme nezávislé lekárne
• záleží nám na odbornosti farmaceutov
• využi benefity družstva Vaša
Pridaj sa k nám!
Naskenuj QR kód a objav pracovné ponuky vo Vašej!


Škandinávska spoločnosť New Nordic už viac ako 30 rokov vyvíja a vyrába širokú škálu výživových doplnkov a kozmetických výrobkov. Dlhoročné odborné znalosti spoločnosti New Nordic v oblasti bylín a vášeň pre kvalitu sú základom všetkých výrobkov. Charakteristická značka strieborného stromu je zárukou čistých škandinávskych výrobkov s vedeckými dôkazmi, ktoré fungujú v harmónii s vaším telom. Sme hrdí na to, že vám môžeme ukázať cestu k väčšej vitalite, pohode a krásnemu vzhľadu.
OVERENÁ KVALITA
OD ROKU 1990
Objavte čaro prírody s New Nordic a kozmetikou, ktorú si vyrobíte sami počas workshopov na KDF 2026! PRIHLÁSTE SA ONLINE ;



Rýchlosť a flexibilita, partnerstvo a dôvera, kreativita a efektívnosť.
Tieto hodnoty sú základom nášho úspechu. Pridajte sa k nám a spolu vytvárajme lepšiu budúcnosť!
Staňte sa súčasťou spoločnosti, ktorá si váži svojich zamestnancov a podporuje ich profesionálny rast.
Klinicky overené lieky
Podporujeme kariérny rast
Kontaktujte nás ešte dnes a zistite viac o možnostiach kariéry v KRKA.


ServierSlovenskojesúčasťoumedzinárodnejnezávislej farmaceutickejskupiny,ktorásazameriavana terapeutickýpokrokaprinášanieinovatívnychriešenív oblastiach,ktorémajúzásadnývplyvnakvalituživota pacientov.Našouprioritoujevždypacientareálny prínosprejehozdravie,pretokladiemedôraznielenna dostupnosťkvalitnýchliekov,aleajnaodbornúpodporu zdravotníckejkomunityazodpovednýprístupkliečbe.

Súčasťounašejidentityjeajzodpovednosťvočiširšejspoločnosti.Podporujeme iniciatívy,ktorémajúodbornýajľudskýrozmerMedzinepatrínapríkladšírenie povedomiaoporucháchpríjmupotravyvrámciprojektuChuťžiť,ktorýzastrešuje neziskováorganizáciaEDISlovensko,o.z.Taktiežsazapájamedodobrovoľníckej iniciatívyakonapríkladNašeMestoapodieľamesanaaktivitáchakoFestivalzdravia. Tietoprojektyvnímameakoprirodzenépokračovanienášhoposlania.Jenašouprioritou prispievaťklepšiemuzdraviuavyššejkvaliteživotanielenprostredníctvomliečby,aleaj prostredníctvomprevencie,vzdelávaniaapodporykomunity.

ServierSlovenskojeprostredím,vktoromsaodbornéambíciestretávajús trvalýmihodnotami,spoluprácouadlhodobouvíziou.Veríme,žefarmaceutická





Našakaždodennáprácastojínaodbornosti, spolupráciadôslednomrešpektovaníetických princípov.Aktívnepodporujemekontinuálne vzdelávaniezdravotníckychpracovníkov,vytvárame priestornaodbornúdiskusiuaprispievamek zvyšovaniupovedomiaoprevenciiasprávnom manažmenteochorení.Veríme,žetomávýznam hlavnevprepájanívedyspraxouaprinášaníriešení, ktorésúdlhodoboudržateľnéaklinickyprínosné.
Medzinašeterapeutickéoblastipatria: spoločnosťponúkaširšívýznamnežsamotnýrecept.Jetozodpovednosť, odbornosťakaždodennápráca,ktoráprináša skutočnúzmenu. kardiovaskulárneochorenia,srdcovézlyhávanie, ischemickáchorobasrdca,depresia,diabetes, onkológia,chronickéžilovéochoreniaahemoroidy




SANDOZ d.d. – organizačná zložka, Žižkova 22B, 811 02 Bratislava, tel.: +421 2 48 200 600, e‑mail: sandoz.slovakia@sandoz.com, www.sandoz.sk
2026/02/1080222/01/2028/01
register farmaceutov, register licencií, zoznam členov.

Projekt interakcieliekov.sk
Projekt Magistraliter
Projekt vysetreniavlekarni.sk
Lekárnické listy
Slovenský lekárnik

Nie je odpad ako odpad
Nesteroidné antiflogistiká a paracetamol v samoliečbe
bolesti a horúčky
Manuál receptúr pre individuálnu prípravu liekov v nemocničných a vo verejných lekárňach
Pacient s kašľom v lekárničo hovorím EBM?
Nutričná terapia pre klinických farmaceutov
Naši odborní zamestnanci dohliadajú na bezpečnosť, účinnosť a kvalitu liekov a tiež zdravotníckych pomôcok, ktoré sa dostávajú k slovenským pacientom.
Väčšina zamestnancov pracuje v sídle štátneho ústavu na Kvetnej 11 v Bratislave a 80% našich zamestnancov tvoria ženy. Pobočky sekcie inšpekcie sa nachádzajú v Topoľčanoch, Žiline, Zvolene a v Košiciach.



PDCO (Pediatrický výbor), HMPC (Výbor pre rastlinné lieky), CAT (Výbor pre lieky na inovatívnu liečbu) alebo COMP (Výbor pre lieky na zriedkavé ochorenia).
Dovolenka nad rámec zákona dokopy až +9 dní ročne. Skrátený pružný pracovný čas 37,5 hod/týždeň.
Home Office minimálne 5 dní/mesiac. Možnosti vzdelávania.
Príspevok do DDS, multisport karta.
Prehľad schválení a terapeutických oblastí

Biologicky podobné lieky dnes pokrývajú 10 kľúčových terapeutických oblastí v EÚ – od onkológie a reumatológie až po endokrinológiu, či zriedkavé ochorenia.
Aj na Slovensku sú biosimilárne lieky kľúčom k udržateľnému zdravotníctvu – prinášajú rovnováhu medzi kvalitou, dostupnosťou a finančnou stabilitou systému. Vďaka biosimilárnym liekom sa rozširuje prístup pacientov k terapiám, ktoré mohli byť pre mnohých nedostupné. Biosimilárne lieky sú kľúčom k dostupnejšej a udržateľnejšej zdravotnej starostlivosti. Výsledkom je viac liečených pacientov a skorší prístup k liečbe.
Infografika vychádza z údajov Medicines for Europe.



Klikni si s Lifbee Academy a naštartuj inovácie.
Prepájame vedcov, IT špecialistov a podnikavcov, aby spolu vytvárali inovácie s pozitívnym dopadom vo sfére Life Sciences a EnviroTech. Od nápadu až po startup.
Čo získaš, ak sa prihlásiš?
Praktické vedomosti, ktoré môžeš hneď využiť
Prístup k odborníkom a firmám
Priestor pre svoje nápady a projekty
Komunitu a podporu aj po programe
Prihlás sa do 30.4.2026
Klikni si s Lifbee aj ty

www.lifbee.com/lifbee-academy

